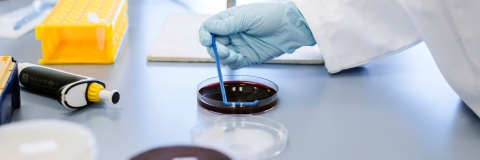
Close up of a gloved hand and some petri dishes

The Institute of Life Sciences and Healthcare (ILSH) promotes an integrated, inclusive and supportive research environment for Research and Innovation (R&I) activities spanning the life sciences and healthcare space.
90% of our research was judged to be internationally excellent or world-leading in terms of originality, significance and rigour in the REF2021 Research Excellence Framework.
Cross-disciplinary R&I activity in ILSH, often in partnership with healthcare and industry, is characterised by its breadth and capability to address important questions on multiple levels to achieve real-world impact.
Research
ILSH represents research across four synergistic R&I Thematic Research Groupings:
Frontier Biomolecular Science
Focused on advancing the understanding and manipulation of biological molecules for discovery

Translational Medicine and Disease
Bridges fundamental scientific research with clinical applications to tackle human diseases

Advanced Therapeutics and Delivery
Develops and optimises delivery systems for targeted therapeutic interventions

Advancing Health and Wellbeing: Innovations, Equity and Care Delivery
Developing innovative solutions to improve healthcare and wellbeing

These Thematic Research Groupings support extensive collaboration within ILSH, with NHS trusts, patient groups, industry, and with national and international research institutes. This extensive network reflects our multidisciplinary approach to research in the biosciences and provides an environment that supports the translation of our fundamental science for societal benefit. This includes, for example, R&I activities within clinical practice, biomedical research, genomics, model organism work, diagnostic development, therapeutics, data science, artificial intelligence, and engineering biology.
Contact us
To get in touch, please contact the Institute of Life Sciences and Healthcare Administrator.





